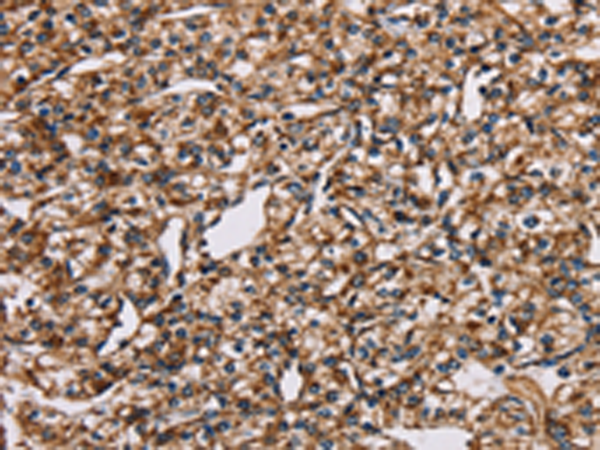

-
分类: 科研抗体货号: P08555别名: CI-75k; CI-75Kd; PRO1304应用: WB,IHC反应种属: Human, Mouse, Rat
-
分类: 科研抗体货号: P08554别名: CI-30应用: WB,IHC反应种属: Human, Mouse
-
分类: 科研抗体货号: P08572别名:应用: WB,IHC反应种属: Human
-
分类: 科研抗体货号: P08553别名: CI15K; CI-15k应用: WB,IHC反应种属: Human, Mouse
-
分类: 科研抗体货号: P08588别名: OS-9; ERLEC2应用: WB,IHC反应种属: Human, Mouse
-
分类: 科研抗体货号: P08570别名:应用: WB,IHC反应种属: Human, Mouse
-
分类: 科研抗体货号: P08552别名: B9; CI-B9应用: WB反应种属: Human, Mouse
-
分类: 科研抗体货号: P08587别名: GC1; OLM4; OlfD; GW112; hGC-1; hOLfD; UNQ362; bA209J19.1应用: WB反应种属: Human
-
分类: 科研抗体货号: P08569别名: NLG1; NEPH3; FILTRIN应用: WB反应种属: Human, Mouse
-
分类: 科研抗体货号: P08550别名: CC6; CI39k; CI-39k; NDUFS2L; SDR22E1应用: WB,IHC反应种属: Human

鄂公网安备42018502007531号
鄂公网安备42018502007531号

